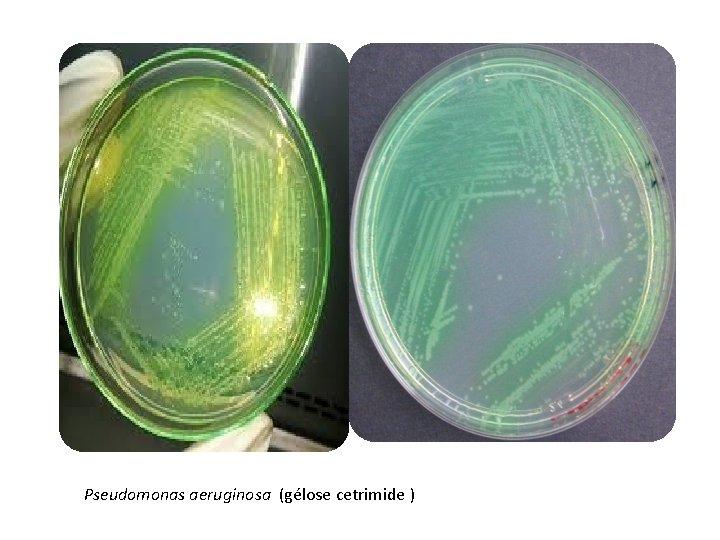
Pseudomonas aeruginosa (gélose cetrimide )

Universit Mohamed KhaiderBiskra Facult des sciences exacte et

Université Mohamed Khaider-Biskra Faculté des sciences exacte et sciences de la nature et de vie Département des sciences de la nature et de vie Pseudomonas aeruginosa Réalisé par: Haif si Haif Asma Djennane Asma Rahal Hadil Année universitaire 2019/2020 Encadré par : M. djouamaa

Plan de travail: q. Introduction. q. Définition. q. Habitat. q v. Echantillon Pouvoir biologique. pathogène q directe. v. Diagnostique Echantillon biologique q. Caractère morphologique. v. Caractère diagnostic direct q culturaux. v. Caractère morphologique q biochimique. v. Caractère culturaux v. Caractère biochimique et enzymatique v. Conclusion

Introduction: Le monde vivants est plein par les bactérie , de très vaste diversité. Qui sont des organismes vivants unicellulaires. Elle sont procaryotes. Il y a des bactéries non pathogènes et pathogènes , et parmi ces dernier Pseudomonas auruginosa: c’est une bactérie ubiquitaire , donc quelle est leur habitat , pouvoir pathogène , les caractères morphologiques et ainsi de suit…?

Définition: Le Pseudomonas aeruginosa, également connu sous le nom de bacille pyocyanique, est une bactérie a Gram négatif aérobie stricte , saprophyte. que l'on trouve partout dans la nature, et en particulier dans les milieux humides et chauds. Habituellement, cette bactérie est peu agressive envers l'homme, mais elle peut devenir pathogène (responsable d'une maladie) dans certaines circonstances.

Habitat : ØGerme ubiquitaire présent dans l’eau , le sol. ØLes plantes (légumes et fruits). Ø le tube digestif. ØL’environnement hospitalier. Øles milieux humides comme les robinets et les tuyauteries et les zones cutanées humides (aisselles, périnée. . . ). ØL’environnement hospitalier.

Pouvoir pathogène: P. aeruginosa est l’exemple type de la bactérie pathogène opportuniste. Les malades particulièrement sensibles sont : Ø les nourrissons. Ø les personnes âgées. Ø les sujets atteints d’affections graves, chroniques, métaboliques (diabète) mais surtout hématologiques ou cancéreuses. Ø Les immunodéprimés. Ø Chez les brûlés.

Échantillon biologique: Le prélèvement se fait par: ØUn échantillon d’eau. ØLBA. (le lavage broncho-alvéolaire) ØUrines. ØLe sphère LCR. ØLe sphère ORL. ØAspiration trachéale. ØCrachats. ØHémocultures.

Diagnostique directe: v Microscopie: Ø Bacilles a Gram négatif , très fins , mobiles , parfois entourés d’un slime. v Culture : Ø Culture sur gélose au sang , BCP , Hektoèn … , incubation en aèrobiose. Ø Possibilité de dissociation des culture. Ø Aspect bleu-vert métallique des colonies. Ø Identification par des testes biochimiques a partir des galerie commercialisées(API , NE)

Caractère morphologique: ØBacilles fin. Ø Gram négatif. ØIls apparaissent isolés ou diplobacilles. ØMobiles (monotriche). ØNon capsulé. ØNon sporulé.

Caractère culturaux: Øse multipliant sur des milieux synthétiques simple : BCP , gélose de chocolat , Hektoén … Ø Elle pousse facilement en 2 heures à une température de 37° C et il peut pousser jusqu’à 41°C et de p. H (6. 5 - 7. 5) Ø Type respiratoire : Aérobie stricte. . ØLa culture très alcaline, répand une odeur aromatique. Après quelques jours, un sédiment visqueux s’accumule en profondeurs. Sur gélose apparaissent des colonies de quelques millimètres de diamètre, plates ou surélevées, opaques, à surface assez dépolie, limite par un bord régulier ou finement dentilé, prenant en vieillissant des reflets métalliques. On peut aussi observer des formes rugueuses ou des formes muqueuses , en 2 à 4 jours, on assiste souvent à un bleuissement ou verdissement des milieux de culture dû aux pigments diffusibles élaborés par la bactérie.
Pseudomonas aeruginosa (gélose cetrimide )

Les Pseudomonas asruginosa sont lactose – (négatif))sont des bactéries non fermentaire

Milieu King A King B Gélose King B

Caractère biochimique ET ENZYMATIQUE: v Métabolisme : La bactérie P. auruginosa possède : Øune oxydase+ et catalase+. o une nitrate -réductase + (réduction des nitrates pouvant aller jusqu'à au stade de N gazeux) Ø un métabolisme oxydatif des sucres appréciable sur milieux MEVAG(milieu pour l'étude de la voie d'attaque des glucides). Ø ADH + , Gel+ ØLe pouvoir protéolytique : liquéfaction de la gélatine en entonnoir puis coupe renversé. v. Production de pigment : la bactérie P. auriginosa produit 2 types de pigment. ils peuvent être mis en évidense dans le milieu de King B et King A. ØPyoverdine : pigment jaune-vert fluorescent , solubles dans l’eau , insoluble dans le chloroforme. ØPyocyanine(spécifique de P. auruginosa): pigment bleu-vert non fluorescent , soluble dans l’eau et le chloroforme.

ONPG LDC ODC ADH TDA H 2 S Mannit ol Urée Indole Catalase _ _ _ +

Diagnostic différentiel • Avec les espèces de Pseudomonas du groupe fluorescens qui peuvent être pigmentées (pyoverdine ) essentiellement • P. fluorescens et P. putida: ces espéces ne poussant pas à 41 °C et sont sensibles à la Kanamycine,

Conclusion: Pseudomonas aeruginosa est un pathogène nosocomial majeur, en particulier chez les patients atteints de mucoviscidose et dans les services de réanimation. Ces souches sont définies par la résistance à au moins trois des quatre principales classes d’antibiotiques anti. Pseudomonas (pénicillines/céphalosporines/monobactames, carbapénèmes, aminosides et fluoroquinolones).

Elles cumulent constamment plusieurs mécanismes de résistance aux antibiotiques (efflux, imperméabilité, modification du site d’action ou inactivation enzymatique), conséquences d’événements génétiques multiples (mutations et/ou transfert horizontal de gènes de résistance). La colistine (polymyxine E) reste active sur la quasi-totalité de ces souches et constitue fréquemment la dernière option thérapeutique disponible, au prix d’un risque non négligeable de néphrotoxicité. (François Barbier et Michel Wolff , 2010)

La prévention Pseudomonas aeruginosa est une bactérie nosocomiale qui cumule de nombreux mécanisme de resistance, donc la prevention c’est mieux que le traitement Hygiène des personnels soignants Hygiène de matériel hospitaliers (lavage des mains, tenues de travail) (Désinfection et stérilisation des instruments • Hygiène de l’environnement • (contrôle de l’air, désinfection des locaux, lutte contre les insectes

Références: • AVRIL J. L. , DABERNAT H. , DENIS F. et MONTEUIL H. , Pseudomonas aeruginosa in BACTERIOLOGIE CLINIQUE, ELLIPSE, PARIS, 1999, p 298312 • RICHARD C. KIREDJAN M. , Méthode de laboratoire pour l'identification des bacilles à Gram Négatifs aérobies stricts, Institut Pasteur, 1995, p 42 -50 • FRENEY J. , HANSEN W. et al, Pseudomonas et Burkholderia in Précis de bactériologie clinique, ESKA 2000 LYON p 1260 -1285 • Site Internet : http: //anne. decoster. free. fr/bgn/pseudo. htm • FRENEY J. , Cours de bactériologie 3 ième année de pharmacie, 1999 • Cystic Fibrosis Foundation. Microbiology and infectious disease in cystic fibrosis. Pediatr Pulmonol 1994; Appendix VIII: 1– 26. J. , Cours de bactériologie 3 ième année de pharmacie, 1999 • Francois B; Michel W ; 2010 Multi drug resistant Pseudomonas aeruginosa: towards a therapeutic dead end ? Med Sci (paris) , 26: 960 -968
- Slides: 20